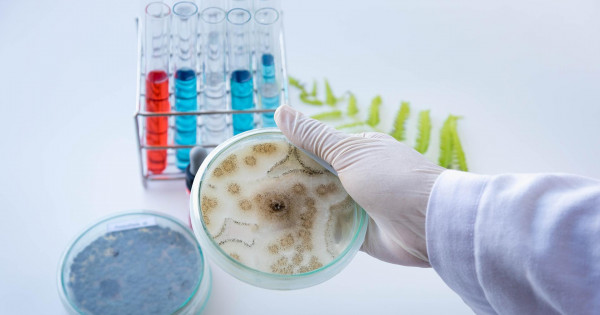

ۇلىبريتانيا ۇكىمەتى ۆاكتسينانى ەكسپورتتاۋدى تەك ءوز ازاماتتارى تولىق ەكپە الىپ بولعاندا عانا جۇزەگە اسىراتىنىن ايتسا, گەرمانيا ەكونوميكالىق ىنتىماقتاستىق جانە دامۋ ءمينيسترى گەرد ميۋللەر دۇنيەجۇزىن قامتيتىن ۆاكتسينالاۋ جۇرگىزۋ ءۇشىن 25 ملرد ەۋرو جەتىسپەي جاتقانىن العا تارتتى. سول سەبەپتەن ەو-عا مۇشە مەملەكەتتەرگە قاراتا قاجەتتى سومانىڭ تەزىرەك جينالۋى ماڭىزدى ەكەنىن ايتتى. سونداي-اق بۇل شارادان اقش, اراب ەلدەرى جانە قىتاي مەن رەسەي دە شەت قالمايدى دەگەن ويىن جەتكىزدى. ال ەۋروكوميسسيا توراعاسىنىڭ ورىنباسارى مارگاريتيس سحيناس وداققا مۇشە ەلدەر ازاماتتارىنىڭ 70 پايىزى شىلدەنىڭ ورتاسىندا ۆاكتسينالاۋ جاساتىپ ۇلگەرەدى دەگەن ءۇمىتى بارلىعىن ايتادى. دۇنيەجۇزىلىك دەنساۋلىق ساقتاۋ ۇيىمى ۆاكتسينامەن قامتىلۋدىڭ دەڭگەيىنە كوڭىلى تولماي, ۇيىم باسشىسى تەدروس گەبرەيەسۋس: «جالپىعا بىردەي جاھاندىق پروبلەماعا جاھاندىق كوزقاراس قاجەت. مۇنداي قيىندىقتىڭ شەشىلۋى جالپىعا بىردەي ىنتىماقتا, بىرلەسكەندە عانا بولادى» دەدى. ول قازىرگى ۋاقىتتا ەكپەنىڭ 76 پايىزىنىڭ 10 ەلگە عانا تيەسىلى ەكەنىنە قىنجىلدى.
ءيا, ىندەت قىسپاعىنان قۇتىلۋدا ۆاكتسيناعا ادامزات بالاسى ۇلكەن ءۇمىت ارتىپ وتىر. الايدا كەيبىرىن ەگۋ بارىسىندا كۇمان تۋعانى دا راس. ماسەلەن, بريتان-شۆەد بىرلەسكەن ءونىمى AstraZeneca-مەن ەگۋدى بىرقاتار ەۋروپا ەلدەرى توقتاتىپ, ارتىنان ەۋروپا دارىلىك ونىمدەر (EMA) اگەنتتىگىنىڭ تەكسەرۋىنەن سوڭ گەرمانيا باستاعان بىرقاتار مەملەكەت AstraZeneca پرەپاراتىن COVID-19-عا قارسى قولدانۋدى قايتا جانداندىردى. سولاي بولعانىمەن بەرليندەگى اتاقتى «شاريتە» ۋنيۆەرسيتەتتىك كلينيكاسىنىڭ رەسمي وكىلى مانۋەلا تسينگل (Manuela Zingl) ناقتى شەشىم قابىلدانعانعا دەيىن AstraZeneca ۆاكتسيناسى جاسى 55-كە دەيىنگى ارىپتەستەرىنە سالىنبايتىنىن حابارلادى. ونىڭ ايتۋىنشا, بۇعان گەرمانيادا ۆاكتسينا سالدىرعان جاس ايەلدىڭ ميىندا ترومبوزدىڭ پايدا بولۋى جايىندا جاڭا اقپاراتتىڭ تاراۋى سەبەپ كورىنەدى. بۇل قادامدى ءالى كۇنگە 55 جاسقا دەيىنگى ازاماتتارىنا وسى ۆاكتسينانى سالدىرماي وتىرعان كانادا وكىمەتى دە قولدايتىنىنا ءسوز جوق. دەگەنمەن ايتا كەتۋ كەرەك, مانۋەلا تسينگل وسىعان دەيىن شاريتەلىك 16 مىڭ قىزمەتكەردىڭ ۆاكتسينالاۋدان وتكىزىلگەنىن جانە كوپشىلىگىنىڭ AstraZeneca قابىلداعانىن, ولاردا ەشقانداي الاڭداتارلىق جاعداي, اسقىنۋدىڭ بولماعانىن جەتكىزدى.
AstraZenecaعا قاتىستى تاعى ءبىر ەلەڭدەرلىك جاڭالىق, ونىڭ ساۋدا بەلگىسىن وزگەرتۋى. 25 ناۋرىزدا كومپانيا شىعارعان شەشىم بويىنشا AstraZeneca ەندى Vaxzevria دەپ اتالماق. ونىڭ پرەپاراتتىڭ ىشكى مازمۇنىنا ەش اسەرى جوق, تەك سىرتى مەن ماركا بەلگىلەنۋىندە عانا وزگەرىس ەنگىزىلەتىن كورىنەدى.
كوروناۆيرۋسقا قارسى مرنك ۆاكتسيناسىنىڭ قاتارىنا جاتاتىن BioNTech/Pfizer جانە Moderna-عا قاتىستى دا ماسەلەلەر بولعانىمەن مۇحيتتىڭ ار جاعىنداعى الپاۋىت ەل – اقش كوروناۆيرۋسپەن كۇرەستە ەتەك-جەڭىن جيىپ 50 ملن-نان استام ازاماتىنا ەكپە سالدىرىپ ۇلگەردى. ەلگە وسى كۇنگە دەيىن 180,6 ملن دوزا Pfizer/BioNTech, Moderna جانە Johnson & Johnson ۆاكتسينالارى جەتكىزىلسە, سونىڭ 145,6 ملن دوزاسى قولدانىلعان. اقش-تىڭ اۋرۋلاردى باقىلاۋ جانە الدىن الۋ جونىندەگى ورتالىعى (CDC) عالىمدارىنىڭ مالىمدەۋىنشە, ۆاكتسينانىڭ ەكىنشى دوزاسىن الۋشىلار قاتارى مولايعان ەكى اپتانىڭ ىشىندە ۆيرۋس جۇقتىرۋ 90 پايىز شەگىندە تومەندەيدى, ال ءبىرىنشى دوزاسىن العاندا ودان تومەنىرەك 80 پايىز شاماسىندا دەپ باعالانعان. ولار وعان بىلتىرعى جەلتوقساننان ناۋرىزعا دەيىن زەرتتەۋشىلەر نازارىندا بولعان 3 950 ەرىكتىنىڭ اۋرۋدى الدىرماعان بەكەمدىگىنە قاراپ باعا بەرگەن كورىنەدى.
ال وڭتۇستىك ازياداعى بىرقاتار ەل ازاماتتارىن COVID-19-عا قارسى ۆاكتسينامەن قامتاماسىز ەتۋدىڭ ءتۇرلى جولدارىن ىزدەستىرىپ جاتىر. فيليپپين, وڭتۇستىك كورەيا, يندونەزيا ايماقتاعى ەلدەردى قامتاماسىز ەتۋدى جوسپارلاعان ءۇندىستاننىڭ ۋاقىتشا AstraZeneca ۆاكتسينالارىن ەكسپورتتاۋدى توقتاتا تۇرۋىنا بايلانىستى وسىنداي قادام جاسادى. ءۇندى تاراپى كەشىكتىرۋدىڭ نەگىزگى سەبەپتەرىنە توقتالماستان, ەلدەگى سارىسۋ ينستيتۋتى COVAX-پەن ارىپتەستىكتىڭ اياسىندا مامىر ايىندا ۆاكتسينانى ەكسپورتتاۋ قايتا جانداناتىنىن حابارلادى. ايتسە دە وڭتۇستىك كورەيا وزدەرىنە ۋادە ەتىلگەن 690 مىڭ دوزانىڭ 432 مىڭىن عانا ءساۋىردىڭ اياعىنا قاراي جەتكىزىلەتىنىنە الاڭداسا, ۆەتنام جاعى تيەسىلى جۇكتىڭ 40 پايىزى عانا جىبەرىلەتىنىنە قىنجىلىس بىلدىرگەن. ال فيلليپين بيلىگى ۆاكتسينا كەشىككەن جاعدايدا قىتاي مەن رەسەيگە يەك ارتاتىنىن مالىمدەپ وتىر.
ۆاكتسينا جاساۋ ءىسىنىڭ قاي ەلدىڭ دە عىلىمي ءارى ەكونوميكالىق الەۋەتىنەن حابار بەرەتىن كورسەتكىشكە اينالعانى راس. وتاندىق عالىمداردىڭ تابىسىن ددۇ مويىنداپ, قازاق ۆاكتسيناسىن ۇمىتكەر رەتىندە تىركەگەنى ءمالىم. بيىل بارلىق سىناقتان وتكەن وتاندىق ۆاكتسينا ومىرگە جولداماسىن الادى دەپ ۇمىتتەنەمىز. ازىرگە قولدانىسقا ەنگەن BioNTech/Pfizer جانە Moderna, AstraZeneca, سپۋتنيك V ءتارىزدى كەڭ تانىمال بولماعانىمەن, تۇرىك باۋىرلاردىڭ ينترانازالدى ۆاكتسيناسى قازىرگى ۋاقىتتا ادامدارعا كلينيكالىق زەرتتەۋدەن وتكىزىلىپ جاتقانىن تۇركيالىق اقپارات اگەنتتىكتەرى حابارلايدى. تۇركيا ونەركاسىپ ءمينيسترى مۇستافا ۆارانكقا سۇيەنە تاراتقان حابارعا سەنسەك, سپرەي ءتارىزدى مۇرىنعا جىبەرىلەتىن ۆاكتسينانىڭ جاقىن ارادا تۇساۋى كەسىلەتىن سياقتى. نەگىزىندە تۇركيادا COVID-19-عا قارسى 6 ۆاكتسينا جاسالۋ ۇستىندە. ىزدەنىستەرى ناتيجەلى بولعان ەردجيەس, حادجەتتەپە, ءمارمارا, اتاتۇرىك, اقدەنيز جانە يىلدىز تەحنيكالىق ۋنيۆەرسيتەتتەرىنىڭ عالىمدارى وسىلايشا تۇركيانىڭ عىلىمداعى الەۋەتىن الەمگە تانىتۋدا.
تاجتاجالعا اينالعان SARS-CoV-2 تىرناعىنان قۇتقارۋشى ۆاكتسينا اتاۋلىعا الەم كوز تىگىپ, وعان قاتىستى ءار جاڭالىققا ەلەڭدەيدى. سوندىقتان ەگۋگە قاراعاندا قولدانىلۋى جەڭىل سپرەي تۇرىنە قىزىعۋشىلىقتىڭ ويانۋى دا زاڭدىلىق ءتارىزدى.





































